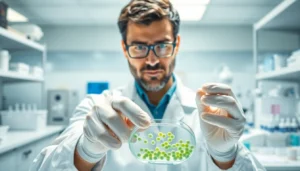

Delicious and Fun Toddler-Friendly Recipes for Healthy Eating Enjoyment
Finding meals that satisfy a toddler’s taste buds while being nutritious can feel like a daunting task. Parents often struggle to balance creativity and healthiness

Finding meals that satisfy a toddler’s taste buds while being nutritious can feel like a daunting task. Parents often struggle to balance creativity and healthiness

When you think of football legends, John Madden’s name inevitably pops up like a surprise touchdown in the final seconds of a game. Known for
When it comes to sexually transmitted infections, most people think of the usual suspects. But what if a notorious bacteria like Pseudomonas aeruginosa crashed the

In a world where health trends come and go faster than a TikTok dance, prebiotic soda is making quite the splash. Imagine sipping on a

When it comes to feeding kids, the struggle is real. They can be picky eaters one minute and adventurous foodies the next. But fear not!

Cooking isn’t just for grown-ups anymore. It’s time to hand over the spatula and let kids unleash their inner chefs! Hands-on cooking for kids not

Imagine a world where kids swap video games for aprons and spatulas. Culinary classes for kids are not just about stirring pots; they’re about sparking

Imagine a kitchen bustling with laughter, tiny hands covered in flour, and the sweet aroma of freshly baked cookies wafting through the air. Cooking parties

In the grand arena of home cooking, every kitchen is a stage for culinary escapades. Whether it’s a daring soufflé that defies gravity or a

In the vast universe of Roblox, where creativity knows no bounds, players often find themselves diving headfirst into a sea of virtual goodies. But as